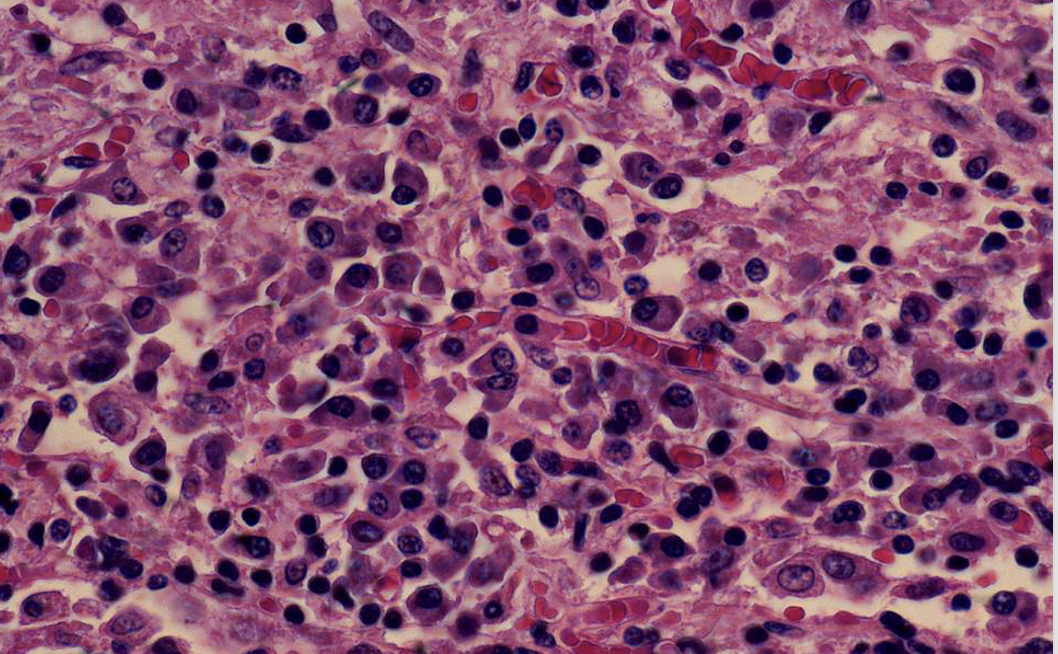

Acute Inflammation, Chemical Mediators
Histamine, prostaglandins, from mast cells
Cytokines from Macs (IL1, TNF, IL6, chemokines)
Acute Inflammation, Stages
-Vasodilatation
-Increased vascular permeability
-Edema
-Leukocyte (esp neuts) recruitment
-Rolling, pavementing, migrating
-Leukocyte activation
-Phagocytosis, killing / degradation

Neutrophils


Chronic Inflammation
Persistent infection
Autoimmune disease
Prolonged exposure to toxin
Chronic Inflammation, Histopathology
Macs, lymphocytes, plasma cells
Granulation tissue, angiogenesis
Scarring fibrosis

Neutrophils in pulmonary alveolar airspaces, acute bronchopneumonia

Interstitial fibrosis and chronic inflammatory cells (lymphocytes), interstitial pneumonia
Chronic Inflammation (lymphocytes and plasma cells)
Chronic Inf, Chemial Mediators
-Activated Macs (IL1, TNF, FGF)
-Activated lymphs (FGF, interferon)

Tuberculous with granulomas
Wound Healing
-Bleeding, clotting, fibrin matrix
-Macs secrete fibroblast growth factor (FGF)
-Fibroblasts make collagenase + remodel
-Angiogenesis granulation tissue
-Fibrous scarring, 1st and 2nd intention
Growth factors in healing
stimulate the function of growth control genes
called proto-oncogenes because mutations in them lead to unrestrained cell proliferation characteristic of cancer (oncogenesis)

Granulation tissue with proliferating capillaries (circled), and fibroblasts (arrowheads)


